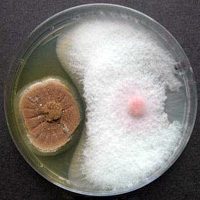

スミリンユーキデルマ(以下デルマと記載)は、土壌の微生物環境及び植物の生育に有用な微生物群“デルマ菌”を高密度で培養し堆肥の発酵過程で添加、定着、増殖させた有用微生物資材です。“デルマ菌”はトリコデルマ等の糸状菌3菌種と細菌類であるバチルス菌で構成されてます。
他の微生物資材との違いは、完熟堆肥に定着させているため、微生物要因とその誘引である土壌の化学性、物理性を同時に改善し、有用微生物の働きを最大限に引き出せることです。
 |
|
| バチルス(Bacillus)の抗生作用を受けて病原フザリウム(Fusarium)菌の菌糸が膨潤し、奇形になった状態 |
|
|
|
デルマ菌は、有機物の分解力と悪玉菌に対して抑止力のある菌が選抜されています。 |
|
デルマは、土太郎、コンパル等の農業用育苗培養土にも添加されています。左図は土太郎、他社培土にキュウリを播種し、そこに病原菌を摂取したものです(上から、土太郎、他社培土A、B)。他社培土では、キュウリが発芽後、直ちに立ち枯れ病を起こしているのに対して、土太郎では全く問題ないことが一目瞭然です。多くの市販培養土は殺菌されていますが、人間の体でも抗生剤に頼りすぎると免疫力が低下するように、病気にかかりやすくなってしまいます。土太郎では漢方的手法によりあえてさまざまな有用菌を混在させることにより、リスクの少ない安心した苗生産を実現します。
|
| |
| 1, |
病害多発地では土壌消毒を実施し、完全にガス抜きをしてください。 |
| 2, |
有用微生物の働きを促進するため、土壌のpHを6.0~7.0に調整してください。 |
| 3, |
ワラ、バークなどの熟成堆肥をすき込んで耕うんし、畝立てしてください。 |
| 4, |
畝立て後、畝にデルマを散布しすみやかに攪拌混合してください。 |
| |
□ 標準施用量
| 使用区 |
単位 |
デルマ |
熟成堆肥* |
| 育苗鉢土 |
1m2 |
30~60kg |
容量比 20~40% |
| 育苗床 |
1m2 |
1~3kg |
3~6kg |
| 圃場 |
10a |
450~600kg |
1~2t |
| 花壇植木 |
1m2 |
5~10% |
10~15% |
|
|
* 熟成堆肥としてスミリンユーキ、バークミンをご使用ください。 |
| |
□使い方いろいろ

〔畝頂にばらまいて、表土10cmとよくかき混ぜる〕 |
|
| 取り扱いの注意 |
| ◯ |
堆肥や一般化学肥料と同時に使用しても差し支えありませんが、未熟堆肥や硫安を多量に含む化学肥料はデルマの効果を低下させます。 |
| ◯ |
殺菌効果のある農薬、除草剤や石灰チッソなどと同時に使用しないでください。(作物の地上部に対する薬剤散布は問題ありません。) |
| ◯ |
デルマを圃場に散布した後は、速やかに土と混合してください。デルマは直射日光の当たらない涼しいところに保管してください。 |
|